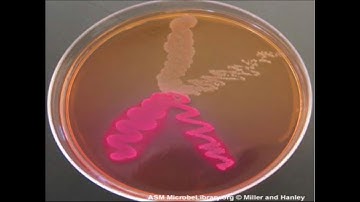
Micro Lab 6: Selective and Differential Media

⬇ DOWNLOAD NOW
Kalau muncul iklan pop-up, tutup lalu klik tombol kembali
Download lagu Lab 6 Intro to Micro secara gratis hanya untuk keperluan promosi. Dukung artis favorit kamu dengan membeli musik original di iTunes atau platform resmi lainnya.
 Introduction To Microbiology
Introduction To Microbiology
 Chapter 1: Introduction to Microbiology
Chapter 1: Introduction to Microbiology
 Taxonomy of Bacteria: Identification and Classification
Taxonomy of Bacteria: Identification and Classification
 Enzymes (Updated)
Enzymes (Updated)
 HOW TO USE A MICROSCOPE #microscope #anatomy #histology
HOW TO USE A MICROSCOPE #microscope #anatomy #histology
Micro Lab 6: Selective and Differential Media
Micro Lab 6: Selective and Differential Media
 tbh he made it farther than we thought he would
tbh he made it farther than we thought he would
 A satisfying chemical reaction
A satisfying chemical reaction